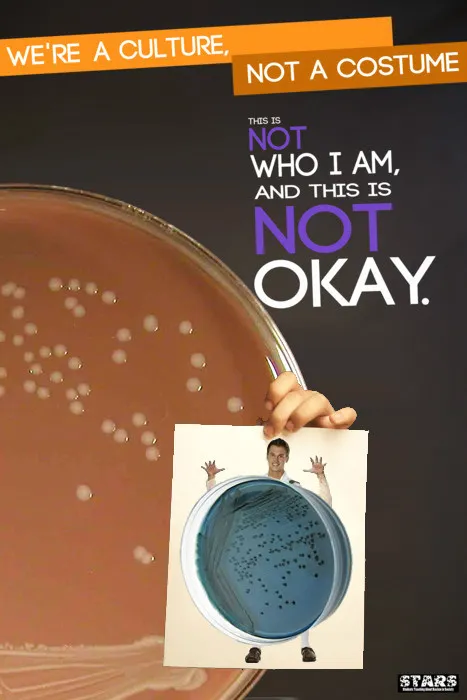

Мы культура, а не костюм!
Благодаря недавнему Хэллоину появился совсем свежий мем, пришедший с запада, и пока что не распространившийся у нас. Авторы решили заставить задуматься молодежь, ударив по специфическим костюмам, которые они используют. Серия гениальных плакатов изображает людей с ярко выраженными национальными чертами, держащих плакаты с надписью:
«Мы культура, а не костюм. Здесь не то, что я есть на самом деле, и это НЕ НОРМАЛЬНО»
Авторы затевали небольшую акцию в рамках университета, однако плакаты ушли в сеть.
ПЛАКАТЫ
ПАРОДИИ
Плакаты достигли таких известных ресурсов, как 4chan и Something Awful. Новым авторам пригодились горе-косплееры и их творчество.
На этом всё. Всем пока =)